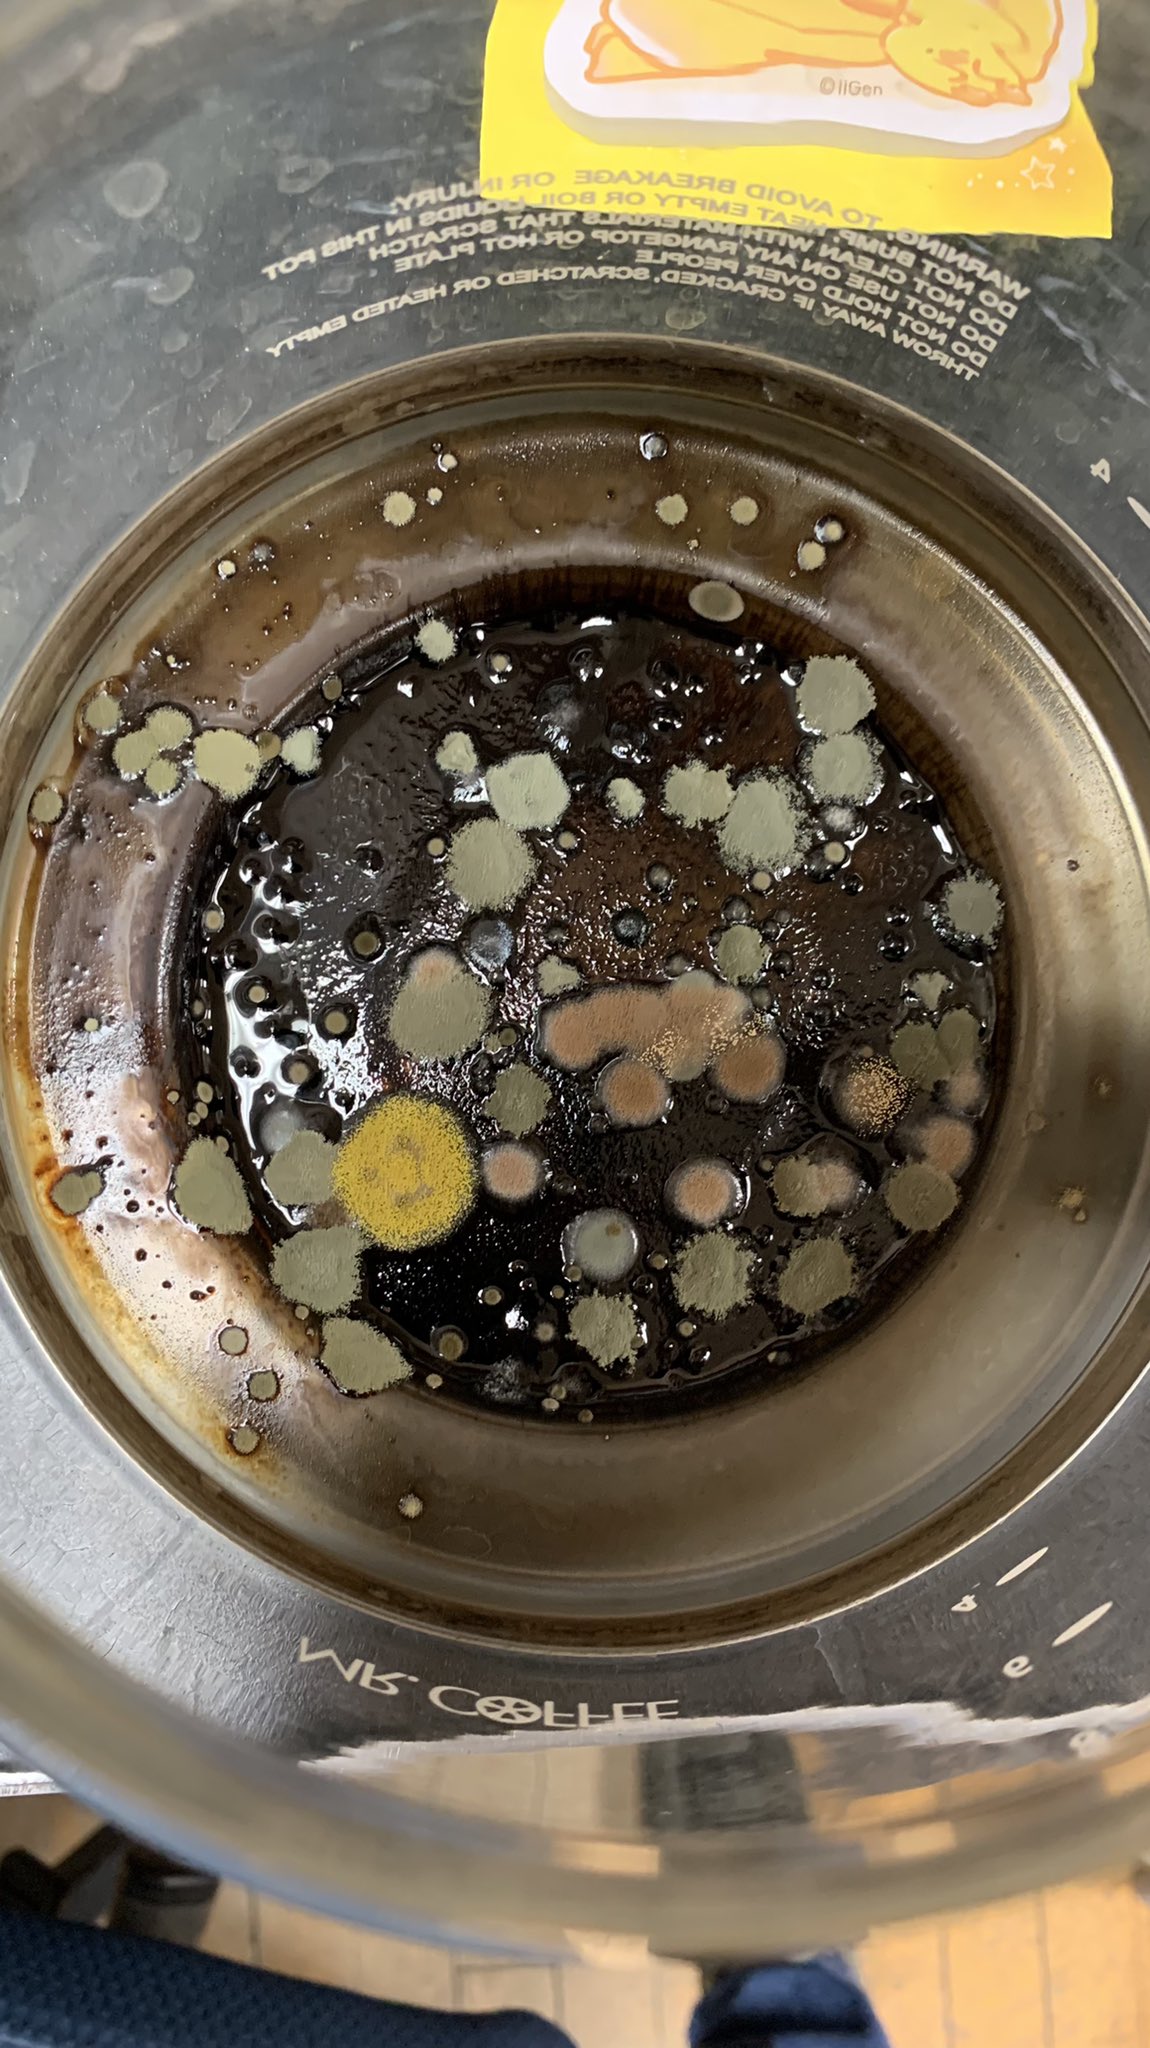

Office Coffee Pot Covid . the office coffee pot? Even shared copiers and printers have become biological hazards, thanks to the spread of the coronavirus. according the aarp.org, the cdc recommends replacing coffee pots and bulk snacks with individually packaged. everything from mass transit to office coffee breaks will be looked at as a potential risk — so what's going to happen. executives say that coronavirus has accelerated trends already changing the workplace: The thoughts for many is on the.
from twitter.com
The thoughts for many is on the. according the aarp.org, the cdc recommends replacing coffee pots and bulk snacks with individually packaged. executives say that coronavirus has accelerated trends already changing the workplace: Even shared copiers and printers have become biological hazards, thanks to the spread of the coronavirus. the office coffee pot? everything from mass transit to office coffee breaks will be looked at as a potential risk — so what's going to happen.
Mengmeng Luo on Twitter "Microbial diversity in the office coffee pot
Office Coffee Pot Covid executives say that coronavirus has accelerated trends already changing the workplace: executives say that coronavirus has accelerated trends already changing the workplace: according the aarp.org, the cdc recommends replacing coffee pots and bulk snacks with individually packaged. The thoughts for many is on the. everything from mass transit to office coffee breaks will be looked at as a potential risk — so what's going to happen. Even shared copiers and printers have become biological hazards, thanks to the spread of the coronavirus. the office coffee pot?
From www.fastcompany.com
How to get WFH employees back to the office? Try free coffee Office Coffee Pot Covid everything from mass transit to office coffee breaks will be looked at as a potential risk — so what's going to happen. the office coffee pot? The thoughts for many is on the. executives say that coronavirus has accelerated trends already changing the workplace: Even shared copiers and printers have become biological hazards, thanks to the spread. Office Coffee Pot Covid.
From counterculturecoffee.com
Office Coffee Subscription Counter Culture Coffee Office Coffee Pot Covid everything from mass transit to office coffee breaks will be looked at as a potential risk — so what's going to happen. executives say that coronavirus has accelerated trends already changing the workplace: according the aarp.org, the cdc recommends replacing coffee pots and bulk snacks with individually packaged. The thoughts for many is on the. Even shared. Office Coffee Pot Covid.
From www.realclearscience.com
'Instant Coffee' COVID19 Tests the Answer to Reopening? RealClearScience Office Coffee Pot Covid according the aarp.org, the cdc recommends replacing coffee pots and bulk snacks with individually packaged. The thoughts for many is on the. the office coffee pot? Even shared copiers and printers have become biological hazards, thanks to the spread of the coronavirus. everything from mass transit to office coffee breaks will be looked at as a potential. Office Coffee Pot Covid.
From www.shutterfly.com
Coffee Pots Beige Ceramic Mug Shutterfly Office Coffee Pot Covid everything from mass transit to office coffee breaks will be looked at as a potential risk — so what's going to happen. the office coffee pot? according the aarp.org, the cdc recommends replacing coffee pots and bulk snacks with individually packaged. executives say that coronavirus has accelerated trends already changing the workplace: Even shared copiers and. Office Coffee Pot Covid.
From www.lavazzapro.co.uk
Bean to Cup coffee machines for offices Lavazza Professional UK Office Coffee Pot Covid the office coffee pot? according the aarp.org, the cdc recommends replacing coffee pots and bulk snacks with individually packaged. executives say that coronavirus has accelerated trends already changing the workplace: Even shared copiers and printers have become biological hazards, thanks to the spread of the coronavirus. everything from mass transit to office coffee breaks will be. Office Coffee Pot Covid.
From rocketsciencelab.co.uk
Covid, Coffee and Catchup join in the conversation! ⋆ Office Coffee Pot Covid according the aarp.org, the cdc recommends replacing coffee pots and bulk snacks with individually packaged. everything from mass transit to office coffee breaks will be looked at as a potential risk — so what's going to happen. Even shared copiers and printers have become biological hazards, thanks to the spread of the coronavirus. executives say that coronavirus. Office Coffee Pot Covid.
From www.aliexpress.com
Aluminum Durable Espresso Coffee Maker Kettle Pot Household Officein Office Coffee Pot Covid everything from mass transit to office coffee breaks will be looked at as a potential risk — so what's going to happen. Even shared copiers and printers have become biological hazards, thanks to the spread of the coronavirus. The thoughts for many is on the. according the aarp.org, the cdc recommends replacing coffee pots and bulk snacks with. Office Coffee Pot Covid.
From www.prestigeservicesinc.com
3 Coffee Bar Ideas to Boost Office Productivity Office Coffee Pot Covid executives say that coronavirus has accelerated trends already changing the workplace: the office coffee pot? Even shared copiers and printers have become biological hazards, thanks to the spread of the coronavirus. according the aarp.org, the cdc recommends replacing coffee pots and bulk snacks with individually packaged. The thoughts for many is on the. everything from mass. Office Coffee Pot Covid.
From www.entrepreneur.com
Don't Be Like the Woman Who Poisoned the Office Coffee Pot Follow Office Coffee Pot Covid executives say that coronavirus has accelerated trends already changing the workplace: the office coffee pot? according the aarp.org, the cdc recommends replacing coffee pots and bulk snacks with individually packaged. Even shared copiers and printers have become biological hazards, thanks to the spread of the coronavirus. The thoughts for many is on the. everything from mass. Office Coffee Pot Covid.
From www.amazon.co.uk
Enfmay Cafetière 350ml, 3 Cup Stainless Steel French Press Coffee Maker Office Coffee Pot Covid according the aarp.org, the cdc recommends replacing coffee pots and bulk snacks with individually packaged. The thoughts for many is on the. the office coffee pot? executives say that coronavirus has accelerated trends already changing the workplace: Even shared copiers and printers have become biological hazards, thanks to the spread of the coronavirus. everything from mass. Office Coffee Pot Covid.
From counterculturecoffee.com
Office Coffee Subscription Counter Culture Coffee Office Coffee Pot Covid the office coffee pot? Even shared copiers and printers have become biological hazards, thanks to the spread of the coronavirus. everything from mass transit to office coffee breaks will be looked at as a potential risk — so what's going to happen. executives say that coronavirus has accelerated trends already changing the workplace: according the aarp.org,. Office Coffee Pot Covid.
From www.system4ips.com
Top 3 Germiest Places In Your Office Office Coffee Pot Covid according the aarp.org, the cdc recommends replacing coffee pots and bulk snacks with individually packaged. the office coffee pot? everything from mass transit to office coffee breaks will be looked at as a potential risk — so what's going to happen. The thoughts for many is on the. executives say that coronavirus has accelerated trends already. Office Coffee Pot Covid.
From mynorthwest.com
Selfishness is infecting our society; just check the office coffee pot Office Coffee Pot Covid according the aarp.org, the cdc recommends replacing coffee pots and bulk snacks with individually packaged. executives say that coronavirus has accelerated trends already changing the workplace: everything from mass transit to office coffee breaks will be looked at as a potential risk — so what's going to happen. The thoughts for many is on the. the. Office Coffee Pot Covid.
From www.huffpost.com
How Coffee Works To Boost Your Productivity HuffPost Life Office Coffee Pot Covid according the aarp.org, the cdc recommends replacing coffee pots and bulk snacks with individually packaged. executives say that coronavirus has accelerated trends already changing the workplace: the office coffee pot? everything from mass transit to office coffee breaks will be looked at as a potential risk — so what's going to happen. Even shared copiers and. Office Coffee Pot Covid.
From www.hull.ac.uk
Scientists invent home COVID19 test using coffee machine capsules Office Coffee Pot Covid The thoughts for many is on the. everything from mass transit to office coffee breaks will be looked at as a potential risk — so what's going to happen. executives say that coronavirus has accelerated trends already changing the workplace: the office coffee pot? according the aarp.org, the cdc recommends replacing coffee pots and bulk snacks. Office Coffee Pot Covid.
From www.amazon.co.uk
Enfmay Cafetière 350ml Stainless Steel French Press Coffee Maker, 13 Office Coffee Pot Covid according the aarp.org, the cdc recommends replacing coffee pots and bulk snacks with individually packaged. executives say that coronavirus has accelerated trends already changing the workplace: Even shared copiers and printers have become biological hazards, thanks to the spread of the coronavirus. the office coffee pot? everything from mass transit to office coffee breaks will be. Office Coffee Pot Covid.
From www.aliexpress.com
3L Stainless Steel Coffee Pot Vacuum Insulated Airpot Coffee Dispenser Office Coffee Pot Covid Even shared copiers and printers have become biological hazards, thanks to the spread of the coronavirus. the office coffee pot? according the aarp.org, the cdc recommends replacing coffee pots and bulk snacks with individually packaged. executives say that coronavirus has accelerated trends already changing the workplace: everything from mass transit to office coffee breaks will be. Office Coffee Pot Covid.
From www.msn.com
Struggling to get coffee stains out? Here's an unlikely trick for your Office Coffee Pot Covid Even shared copiers and printers have become biological hazards, thanks to the spread of the coronavirus. The thoughts for many is on the. executives say that coronavirus has accelerated trends already changing the workplace: everything from mass transit to office coffee breaks will be looked at as a potential risk — so what's going to happen. the. Office Coffee Pot Covid.